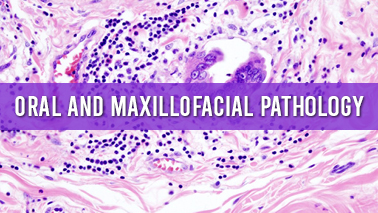
Peers Alley Media: Oral and Maxillofacial  Pathology
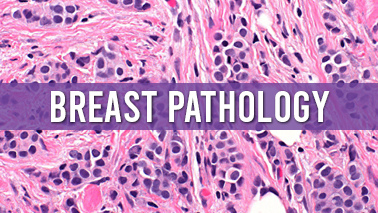
Peers Alley Media: Breast Pathology

Primary goal of attending an international conference is to present a paper to the experts and influencers. It gives you a platform to exchange your interest-related thoughts, paving the way for possible future collaborations.

Use this platform to build connections with an elite group of wise men and women to enhance your intellect. Young entrepreneurs, this is a great platform to connect with your peers.

Knowledge is Power. Knowledge teaches skills. Skills define excellence. Use this platform to become cognizant of your interest area to achieve excellence in your domain.

Attending a conference give you opportunity to get your abstract or paper published in conference proceedings

Meet and greet a myriad of industry professionals and academia experts with common interest. Every meal will be an opportunity to meet and interact with fellow researchers, attendees and experts.

Expand your professional competency and learn useful tips and tricks of your industry in our skill-building workshops.

Explore insights on recent advancements, new equipment, new techniques, and unpublished data, learn from thought-leaders and get to network with a great line up of speakers.

Our exhibits floor offers the attendees with a dynamic display of the latest products with cutting-edge technology.

Investing in you is the best investment. Peers Alley conferences give the patrons with a feeling of the serendipity of real learning, skill development in strategic workshops, networking and start-up opportunities, thus, is value for money.

Attending the conference gives you much needed break from your regular duties. It also allows you to explore new cities, culture and meet new people. You will feel energized and rejuvenated to return to the university and continue with the job after attending the conference.
Conferences are vital forum for academic researchers and business leaders. "It involves multiple presentations, interactive breakout sessions, hands-on product demonstrations and unrivalled networking opportunities".
We have invited some of the world's most sought-after keynote speakers, experts, brand ambassadors, and industry leaders to share their thoughts and ideas with our conference guests.
Register Now
On behalf of the Peers Alley Media conferences, it is my pleasure to invite all Pathologist, Research Practicing Pathologist, Lab technicians, Biomedical Scientists, and Students from all over the world to attend the Euro Pathology Congress from March 23-24, 2020 Paris, France.
Euro Pathology 2020 meeting shares a knowledge into the ongoing exploration and front line innovations, which additions gigantic enthusiasm with the goliath and rich nearness of adepts, youthful and splendid specialists, business agents and capable understudy networks.
Euro Pathology's meeting will probably unite, a multi-disciplinary gathering of researchers and specialists from everywhere throughout the world to present and trade get through thoughts identifying with the pathology. It advances top level research and to globalize the quality research when all is said in done, subsequently making exchanges, introductions all the more universally aggressive and concentrating consideration on the ongoing exceptional accomplishments in the field of pathology, and future patterns and needs.
Since this conference covers very global aspects on physics from very fund a diagnostic issue to practical application of the principle of pathology, anyone interested in future progress of pathology should not miss. We're anticipating a magnificent gathering with extraordinary researchers from various nations around the globe and sharing new and energizing outcomes in pathology, which will be held in Paris, France.
Yours Sincerely
Euro Pathology Organizing Committee
Paris, France
As a member of Peers Alley Media, I am pleased to welcome you all to the conference “Euro Pathology Congress 2020”.
Pathology conference will provide a platform for pathologists, research practicing pathologists, directors, deans, research professionals, laboratory heads, lab managers, lab technicians, laboratory professionals, medical/ biomedical scientists, professors, associate professors, assistant professors, research fellow, medical students, nurses. In recent years, pathology has been expanded throughout the global for treatment in all diseases.
Peers Alley Media welcomes pathologists, physicians, nurses, lab technicians, medical and biological scientists, research practicing pathologist and student representatives to be part of it.
We trust that this gathering will give a chance to revive existing contacts and start crisp ones with your friends from around the world. It is our pleasure and respect to welcome you to the "Euro Pathology congress 2020" in Paris, France, planned for March 23-24, 2020.

Clinical Pathology is an open access, peer inspected worldwide diary that spotlights on and requests original copies that address all parts of pathology, translational research, essential research concentrating on biochemical and sub-atomic components associated with pathogenesis, the hereditary premise of pathology, resistant intervened pathogenesis, pharmacogenomics, bioinformatics, accuracy drug, novel treatments, disease control and medicinal microbiology. If you don't mind see the Aims and Scope tab for additional data.
Sub tracks:
• Pathogenesis • Hematopathology • Transfusion medicine • Immunopathology • Medical microbiology • Molecular pathology • Biochemical pathology • Molecular diagnostics • Histopathology • Cytogenetics • Virology • Parasitology • Microbial virulence • Pharmacogenomics • Translational Research • Precision medicine • Novel therapies • Bioinformatics
Tags
Forensic Pathology Conferences
Cancer Science Conferences
Wound Healing Conferences
Medicine Conferences
Microbiology Conferences
Oral and Maxillofacial Pathology Conferences
Molecular Pathology Conferences
Precision medicine Conferences
General Medical Pathology Conferences
Medical Jurisprudence Conferences
Hematopathology Conferences
Medical Training and Accreditation Conferences
Minimally-Invasive Procedures Conferences
Immunology Conferences
Cancer Pathology Conferences

Human Pathology is intended to bring data of clinic pathologic criticalness to human infection to the research facility and clinical doctor. It presents data drawn from morphologic and clinical research center examinations with direct significance to the comprehension of human maladies. Hypothetical and test pathology and sub-atomic science appropriate to human illness are incorporated. This basic diary is all around shown with uncommon propagations of photomicrographs and infinitesimal life structures.
Sub tracks:
• Bacteriology • Staphylococcus • Gonococcus • Bacillus anthricis • Salmonella typhi • Paracytology • Protozoa Plasmodium • Helmintology • Nematodes • Ascaris lumbricoides
Tags
Hematology Conferences
Pathology Meetings
Immunopathology Conferences
Oncology Conferences
Histopathology Conferences
Cancer Science Conferences
Anatomical Pathology Conferences
Dermatopathology Conferences
Pathogen Conferences
Inflammation Conferences
Neuropathology Conferences
Epidemiology Conferences
Spectroscopy Conferences
Clinical Pathology Conferences
Pulmonary Pathology Conferences

Histopathology is a worldwide diary planned to be of handy incentive to careful and symptomatic histopathologists, and to specialists of human illness who utilize histopathological strategies. The basic role is to distribute propels in pathology, specifically those appropriate to clinical practice and adding to the better comprehension of human disease.It distributes histopathological material having clinical application in the investigation of human ailment and incorporates electron tiny histochemical, immunological and strong trial considers where essential.
Sub tracks:
• Cardiovascular system • Coronary heart disease • Hypertension • Hemopoietic and lymphoid system • Leukemia • Lymphoma
Tags
Spectroscopy Conferences
Pathophysiology Conferences
Immunology Conferences
Inflammation Conferences
Surgical Pathology Conferences
Oral and Maxillofacial Pathology Conferences
Medical Microbiology Conferences
Diagnostic Immunology Conferences
Precision medicine Conferences
Cytopathology Conferences
Hematopathology Conferences
Hematology Conferences
Pathogen Conferences
Hemodynamics Conferences
Etiology Conferences

The diary spotlights progressing propels in the employments of electron tiny and immunohistochemical systems, connections of ultrastructural information with light microscopy, histochemistry, immunohistochemistry, organic chemistry, cell and tissue refined, electron test examination, and significant new analytical, clinical, and indicative EM techniques. The diary is subsidiary with the Society for Ultrastructural Pathology and EuroCellPath.
Sub tracks:
• Structural basis of cell injury • Response to cellular injury
• Cell death • Organelle pathology • The cell surface • Intracellular trafficking
Tags
Pathophysiology Conferences
Wound Healing Conferences
Pathology Conferences 2020 USA
Medical Diagnosis Conferences
Microbiology Conferences
Hematopathology Conferences
Pathology Meetings
Cancer Pathology Conferences
Pulmonary Pathology Conferences
Clinical Pathology Conferences
Neuropathology Conferences
Diagnostic Immunology Conferences
Immunopathology Conferences
Micrography Conferences
Parasitology Conferences

Cytopathology is ordinarily used to explore illnesses including a wide scope of body destinations, regularly to help in the conclusion of malignant growth yet in addition in the determination of some irresistible ailments and other incendiary conditions. For instance, a typical utilization of cytopathology is the Pap smear, a screening device used to distinguish precancerous cervical injuries that may prompt cervical malignant growth. Cytopathologic tests are once in a while called smear tests in light of the fact that the examples might be spread over a glass magnifying instrument slide for consequent recoloring and tiny assessment. Nonetheless, cytology tests might be set up in different manners, including cytocentrifugation. Various kinds of smear tests may likewise be utilized for malignant growth determination. In this sense, it is named a cytologic smear.
Sub tracks:
• Clinical & Molecular Cytopathology • Cytopathology & Disease diagnosisn • Cytopathology of Cytogenetics • General Cytopathology & Immunocytochemistry • Cytopathology Case Reports
Tags
Pathology Conferences 2020 Middle East
Wound Healing Conferences
Oral Pathology Conferences
Psychopathology Conferences
Medicine Conferences
Micrography Conferences
Cancer Science Conferences
General Medical Pathology Conferences
Minimally-Invasive Procedures Conferences
Clinical Chemistry Conferences
Hematology Conferences
Cytopathology Conferences
Telepathology Conferences
Spectroscopy Conferences
Neuropathology Conferences

Careful pathology is the examination of tissues removed from living patients in the midst of medical procedure to dissect an ailment and choose a treatment plan. It is answerable for the histological finding of biopsies and careful resections of significant organ frameworks Regularly, the careful pathologist gives exchange organizations in a wide combination of organ signs and subspecialties.This division incorporates areas of bosom pathology, cardiopulmonary pathology, Dermatopathology, gastrointestinal pathology, genitourinary pathology, head and neck pathology, hematopathology, hepatobiliary pathology, renal pathology, skeletal and delicate tissue pathology.
Sub tracks:
• Anatomical Pathology • Histopathologics Examination • Surgical Pathology Reports
Tags
Micrography Conferences
Transfusion Medicine Conferences
Dermatopathology Conferences
Anatomical Pathology Conferences
Clinical Chemistry Conferences
Clinical Pathology Conferences
Molecular Pathology Conferences
Hemodynamics Conferences
Pathology Conferences 2020 Asia
Microbiology Conferences
Oral and Maxillofacial Pathology Conferences
Medicine Conferences
Pathology Conferences 2020 USA
Cytopathology Conferences
Neuropathology Conferences
The distinguishing strength oral and maxillofacial pathology is stressed over assurance and examination of the conditions and final products of infections affecting the oral and maxillofacial region. It is every so often seen as a quality of dentistry and pathology. At times the term head and neck pathology is used rather, anyway this may recommend that the pathologist oversees otorhinolaryngologic issue (for instance ear, nose and throat) despite maxillofacial issue. In this activity there is some spread between the expertise of head and neck pathologists and that of endocrine pathologists. The clinical appraisal and finish of oral mucosal diseases are in the degree of oral and maxillofacial pathology specialists and oral medication masters, the two controls of dentistry. Right when a moment appraisal is required, a biopsy is taken, and imperceptibly observed by a pathologist.
Sub tracks:
• Developmental defects of the oral and maxillofacial • Orofacial clefts • Commissural lip pits • Pulpal and peripical disease • Secondary and tertiary disease
Tags
Microscopy Conferences
Telepathology Conferences
Histopathology Conferences
Renal pathology Conferences
Immunopathology Conferences
Inflammation Conferences
Hematopathology Conferences
Clinical Pathology Conferences
Microbiology Conferences
Medicine Conferences
Pathology Meetings
Pathogen Conferences
Medical Diagnosis Conferences
Minimally-Invasive Procedures Conferences
Precision medicine Conferences

An illness is a notable, parasitic which will simply duplicate inside different .A totally imitated contamination is called virion and it contains two essential parts, nucleic ruinous and a protein coat which is capsid. The capsid guarantees the innate material and tendencies of the contamination to join to the outside of the specific target receptor of the host.The capsid ensures the hereditary material and causes the infection to append to the outside of the particular objective receptor of the host.
Virology has become widely more evidently as a critical to deal with the assessment of the physiology and acquired attributes that consolidates the uncommon proteins and nucleic acids. Infections are abused as gadgets inside the assessment of those basic and biochemical issues.
Sub tracks:
• Isolation of tobacco mosaic virus • Size and shape of viruses
• The cryptogram • The antigenic nature of viruses • The genetic economy of multi component system
Tags
Medicine Conferences
Surgical Pathology Conferences
Oral Pathology Conferences
Speech-language Pathology Conferences
Surgical Pathology Conferences 2020
Clinical Chemistry Conferences
Precision medicine Conferences
Histopathology Conferences
Microbiology Conferences
Hematopathology Conferences
Psychopathology Conferences
Pathogen Conferences
Pathology Conferences 2020 Middle East
Telepathology Conferences
Renal pathology Conferences

Pediatric ophthalmology is a sub-strength of ophthalmology which manages eye illnesses, visual improvement, and vision care in kids. Master that is able to perform propelled eye medical procedure yet on deal with kids' eye issues exploitation glasses and meds is pediatric ophthalmologist. A few masters and elective doctors allude therapeutic strength patients to a medicinal claim to fame ophthalmologist for assessment and the board of visual issues on account of youngsters' unmistakable needs. moreover, to kids with evident vision issues, kids with head turns, head tilts, shut of the eyes, or most popular head stances (torticollis) square measure commonly expressed a therapeutic claim to fame master for investigation. Medicinal strength ophthalmologists by and large furthermore oversee grown-ups with eye development issue, (for example, move or squint) on account of their nature with strabismus conditions.
Sub tracks:
• Leukocoria • Strabismus • Convergence insufficiency
Tags
Cytopathology Conferences
Medical Diagnosis Conferences
Pathology Meetings
Oral and Maxillofacial Pathology Conferences
Pathogenesis Conferences
Anatomical Pathology Conferences
Cancer Science Conferences
Hematology Conferences
Wound Healing Conferences
Parasitology Conferences
Diagnostic Immunology Conferences
Neuropathology Conferences
Surgical Pathology Conferences
Microscopy Conferences
Pathology Conferences 2020 Europe

All multi cell animals and plants rely upon undeveloped cells to create from a single cell into an adult and it empowers our bodies to gather new tissue, for instance, new muscle when we work out. It reliably replaces the numerous particular cells in our body in case they are depleted or hurt. All things considered, every single undifferentiated life form fall into three unmistakable social affairs embryonic juvenile microorganisms are pluripotent cells, which infers they can isolate into all of the sorts of specific cells in the body-Tissue undeveloped cells can both self-energize and offer climb to something like one progressively explicit cell type-Induced pluripotent stem (IPS) cells: These telephones can be created from adults, keeping up a vital good ways from the ethical concerns related with research using human nascent life forms.
Sub tracks:
• Resident stem cells in kidney tissue • Pancreatic stem cells • Resident neural stem cells • Resident stem cell in skin • Lung resident stem cells • Skeletal resident stem cells • Cardiac stem cells
Tags
Ischemia Conferences
Medical Diagnosis Conferences
Parasitology Conferences
Immunology Conferences
Pathogen Conferences
Spectroscopy Conferences
Inflammation Conferences
Immunopathology Conferences
Pathology Conferences 2020 Europe
Immunology Conferences
Medical Jurisprudence Conferences
Hemodynamics Conferences
Cancer Science Conferences
Wound Healing Conferences
Microscopy Conferences

Anatomical pathology is a restorative claim to fame related with the finding of ailment dependent on the naturally visible, infinitesimal, biochemical, immunologic and sub-atomic assessment of organs and tissues.
Molecular pathology is an advancing branch inside pathology which is moved in the examination and examination of malady through the examination of particles inside organs, tissues or organic liquids. Atomic pathology imparts a few attributes of training to anatomic pathology just as clinical pathology, sub-atomic science, organic chemistry, proteomics, and hereditary qualities, and is now and again considered as a "hybrid" branch. It is multi-disciplinary in nature and spotlights essentially on the sub-infinitesimal qualities of the ailment. A key thought is that progressively exact conclusion is conceivable when the finding depends on both the morphologic varieties in tissues (customary anatomic pathology) and on atomic testing.
Sub tracks:
• Molecular diagnostic pathology • Forensic pathology • Microbiology for the surgical pathologist • Cytopathology
Tags
Dermatopathology Conferences
Surgical Pathology Conferences 2020
Pathology Conferences 2020 Europe
Histopathology Conferences
Pathology Conferences 2020 Middle East
Molecular Pathology Conferences
Microbiology Conferences
Pathology Meetings
Medical Training and Accreditation Conferences
Pathogenesis Conferences
Medical Microbiology Conferences
Medicine Conferences
Pathology Conferences 2020 Asia
Microbiology Conferences
Psychopathology Conferences

Tumor is a get-together of diseases incorporating surprising cell advancement with the likelihood to spread to various pieces of the body .It can be either kindhearted or threatening malignant growth that has no physiological capacity and emerges from uncontrolled generally fast cell proliferation.The pathology identified with tumors is known as malignant growth pathology. It is the undertaking of the careful pathologist to give an exact, explicit, and adequately exhaustive analysis to empower the clinician to build up an ideal arrangement of treatment and, to the degree conceivable, gauge forecast of disease through obsessive report.
Sub tracks:
• Screening and Diagnosis • Grading and Staging of cancer • Pathophysiology • Epigenomics and Cancer Risk Factors • Cell Biology and Tumor Biology • Stem Cells and Cancer of Cancer • Tumor Immunology • Molecular pathology • Imaging and Radio oncology • Role of pathology in cancer diagnostics
Tags
Telepathology Conferences
Pathophysiology Conferences
Forensic Pathology Conferences
Immunology Conferences
Microbiology Conferences
Medicine Conferences
Ischemia Conferences
Oral and Maxillofacial Pathology Conferences
Hematology Conferences
Dermatopathology Conferences
Inflammation Conferences
Neuropathology Conferences
Diagnostic Immunology Conferences
Hematopathology Conferences
Hematopathology Conferences
Bosom Pathology can help in knowing the phase of a disease and the reviewing of malignant growth that is an estimation of the degree of the tumor and its spread.Breast contaminations can be grouped either with clutters of the integument, or disarranges of the regenerative structure. A larger piece of bosom disorders which can be affirmed with pathology report.
Sub tracks:
• Breast Cancer Surgery • Breast Cancer Therapy • Benign and malignant Breast Cancer • Staging and grading of Breast Cancer • Common and Uncommon Breast Cancers • Common and Uncommon Breast Cancer
Tags
Telepathology Conferences
Pathology Conferences 2020 Europe
Neuropathology Conferences
Forensic Pathology Conferences
Inflammation Conferences
Immunology Conferences
Speech-language Pathology Conferences
Pathology Conferences 2020 Middle East
Dermatopathology Conferences
Cytopathology Conferences
Ischemia Conferences
Surgical Pathology Conferences
General Medical Pathology Conferences
Pathophysiology Conferences
Pulmonary Pathology Conferences

Pediatric gastroenterology is a program that for the most part centers around inquiring about fiery entrail ailment, irresistible loose bowels, and motility issue which are essentially connected with gastrointestinal intricacies. Stomach related issue are ordinarily seen in youngsters because of absence of nutritious nourishment prompting the manifestations like stomach torment and so forth. GIT and Brain are firmly associated, and their useful conditions are connected because of a mix of additional affectability of the GI tract prompts the adjustments in the motility or development of the stomach related framework. Human stomach and digestion tracts consistently keep the nourishment moving and a few people feels this is more strongly than other individuals. These conditions are regularly watched, now and again keep running in families, and are typically found in people who are generally sound. Kids who are confronting this issue more often than not encounter intermittent agony in the midriff.
Sub tracks:
• Lactose Intolerance • Food allergies or Intolerances • Severe or sophisticated gastro esophageal reflux unwellness (reflux or GERD) • Gastrointestinal Disorders • Necrotizing enterocolitis • Short intestine syndrome • Inflammatory intestine unwellne
Tags
Clinical Pathology Conferences
Anatomical Pathology Conferences
Pathogenesis Conferences
Cancer Pathology Conferences
Psychopathology Conferences
Epidemiology Conferences
Etiology Conferences
Oral Pathology Conferences
Histopathology Conferences
Medicine Conferences
Minimally-Invasive Procedures Conferences
Spectroscopy Conferences
Pulmonary Pathology Conferences
Telepathology Conferences
Diagnostic Immunology Conferences

Delicate tissue pathology is the subspecialty of careful pathology which manages the finding and portrayal of neoplastic and non-neoplastic maladies of the delicate tissues, for example, muscle, fat tissue, ligaments, sash, and connective tissues. Numerous malignancies of the delicate tissues are trying for the pathologist to analyze through gross assessment and microscopy alone, and extra apparatuses, for example, immunohistochemistry, electron microscopy, and sub-atomic pathology strategies are in some cases utilized to acquire an authoritative finding.
Sub tracks:
• Clinical and pathological aspects • Soft tissue pathology infections
Tags
Hematopathology Conferences
Microbiology Conferences
Forensic Pathology Conferences
Inflammation Conferences
Immunology Conferences
Renal pathology Conferences
Pathology Conferences 2020 USA
Epidemiology Conferences
Histopathology Conferences
Hematology Conferences
Environmental Pathology Conferences
Micrography Conferences
Pathology Conferences 2020 Europe
Medical Training and Accreditation Conferences
Medical Microbiology Conferences

Youngsters who are experiencing any kind of blood dyscrasia or malignant growth are considered under the class of Pediatric Hematology. A pediatric hematologist/oncologist is the specialists who have the skill and capabilities to recognize, analyze and treat juvenile patient and fix from the disorder. Pediatric hematologists/oncologists treat youths and youngsters from birth through youthful adulthood to fix the patient from the savage infection. They routinely take a shot at the consideration and treatment of patients with hematological sicknesses. Albeit a portion of the work is additionally identified with hematology research center survey blood movies and bone marrow slides under the magnifying instrument, translating different hematological test outcomes and blood thickening test outcomes.
Sub tracks:
• Hemophilia and idiopathic thrombocytopenic purpura • Hymphoma and leukemia (cancers) • Hemoglobinopathies
Tags
Pathology Conferences 2020 USA
Pathogen Conferences
General Medical Pathology Conferences
Speech-language Pathology Conferences
Microbiology Conferences
Neuropathology Conferences
Medical Diagnosis Conferences
Cytopathology Conferences
Oral and Maxillofacial Pathology Conferences
Anatomical Pathology Conferences
Hemodynamics Conferences
Medicine Conferences
Microscopy Conferences
Medical Training and Accreditation Conferences
Wound Healing Conferences

Cell Therapy consolidates a treatment wherein cell material is saturated into a living cell. For instance, T cells arranged for battling hurt cells by strategies for cell-interceded security might be blended over the scope of immunotherapy. Cell Therapy is the cell adjustments at the sub-nuclear level. Take the chemotherapy in oncology for instance, it means to murder the telephone by passing on poisonous executives to the telephone, while Molecular medications could plan to end the telephone division without essentially butchering the telephone, for example, planning to achieve senescence whose remedial procedure, levels of unsafe experts, and mechanical gatherings for passing on the harmfulness could all be all things considered not equivalent to in a general sense executing the telephone.
Sub tracks:
• Genetically modified T cells • Chimeric antigen receptor T cells • Beyond T cells • Natural killer cells • Dendritic cells in hematopoietic cell transplantation • Gene therapy • Gene therapy for neoplastic hematology in transplant setting • Gene therapy for nonmalignant hematology
Tags
Cancer Science Conferences
Histopathology Conferences
Cancer Pathology Conferences
Epidemiology Conferences
Microbiology Conferences
Surgical Pathology Conferences
Immunology Conferences
Medical Diagnosis Conferences
Minimally-Invasive Procedures Conferences
Clinical Chemistry Conferences
Pathology Conferences 2020 USA
Pathology Conferences 2020 Middle East
Pathogenesis Conferences
Oral and Maxillofacial Pathology Conferences
Microbiology Conferences

Phytopathology otherwise called Plant Pathology incorporates the investigation of plant maladies, their causes and components by which illnesses happen, ailment causing operators, and how to control sicknesses. These sicknesses are brought about by living beings, for example, organisms, microorganisms, infections, protozoa, and parasitic plants; and furthermore by non-living operators, for example, air toxins and different ecological elements. This is an interdisciplinary science field that incorporates learning of herbal science, microbiology, nature, hereditary qualities, organic chemistry, atomic bio logy, crop science, soil science, and physiology.
Veterinary Pathology is the branch in science where investigation of animal illnesses happens. Veterinary pathologists are specialists of veterinary drug who have practical experience in the conclusion of maladies through the assessment of creature tissue and body liquids.
Sub tracks:
• Pyto pathology • Parasitism and disease development • Parasitism and pathogenicity • Dissemination of the pathogen • Effects of pathogens on plant physiological functions • Effects of pathogens on host plant respiration •Effect of pathogens on plant growth • Veterinary pathology • Degeneration and necrosis • Disturbances of metabolism • Disturbances of growth and differentiation of tissues • Organs of special tissues • Neoplasia
Tags
Pathophysiology Conferences
Pathology Conferences 2020 USA
Dermatopathology Conferences
General Medical Pathology Conferences
Microbiology Conferences
Micrography Conferences
Hematopathology Conferences
Microscopy Conferences
Pathology Conferences 2020
Spectroscopy Conferences
Transfusion Medicine Conferences
Ischemia Conferences
Pathology Meetings
Oral Pathology Conferences
Cancer Pathology Conferences

Renal pathology is a subspecialty of anatomic pathology that manages the finding and portrayal of medicinal infections (non-tumor) of the kidneys. In the scholarly setting, renal pathologists work intimately with nephrologists and transplant specialists, who commonly acquire demonstrative examples through percutaneous renal biopsy. The renal pathologist must incorporate discoveries from light microscopy, electron microscopy, and immunofluorescence to acquire a complete conclusion. Medicinal renal sicknesses may influence the glomerulus, the tubules and interstitium, the vessels, or a mix of these compartments.
Dermatopathology is a partner claim to fame of dermatology and pathology and to a lesser degree of careful pathology that spotlights on the examination of cutaneous contaminations at a microscopic and nuclear level. It also incorporates assessments of the potential explanations behind skin diseases at a basic level. Dermatopathologists work in cozy association with clinical dermatologists. In all honesty, most of them are arranged in a general sense in dermatology themselves. Dermatologists can see most skin afflictions in perspective on their appearances, anatomic spreads, and lead. From time to time, in any case, those criteria don't empower a definitive end to be made, and a skin biopsy is taken to be examined under the amplifying instrument or are at risk to other nuclear tests.
Sub tracks:
• Nephrocytosis •Transplanted surgeries • Renal vein thrombosis • Acute renal infarction • Massive renal infarction • Hypogranulosis • Regular acanthosis • Hyperkeratosis • Perivascular lymphohistiocytic infiltrate • Neutrophils in stratum corneum and squamous cell layer
Tags
Pathology Conferences 2020 Middle East
Surgical Pathology Conferences 2020
Immunology Conferences
Etiology Conferences
Medical Jurisprudence Conferences
General Medical Pathology Conferences
Surgical Pathology Conferences
Ischemia Conferences
Diagnostic Immunology Conferences
Anatomical Pathology Conferences
Pathology Conferences 2020 Europe
Pathology Conferences 2020
Pathology Conferences 2020 USA
Immunology Conferences
Cytopathology Conferences

Clinical pathology additionally named as Clinical investigation or Clinical or Medical Biology. It is a therapeutic area that is related with the examination of sickness fixated on the research center investigation of organic liquids, for example, pee, blood and tissue homogenates or concentrates utilizing the apparatuses of science, hematology, microbiology and atomic pathology. This area needs a restorative residency.
Hematopathology or hemopathology is the investigation of infections and clutters influencing platelets, their creation, and any organs and tissues engaged with hematopoiesis, for example, bone marrow, the spleen, and the thymus.[1][2] Diagnoses and treatment of illnesses, for example, leukemia and lymphoma regularly manage hematopathology; strategies and innovations incorporate stream cytometry studies and immunohistochemistry.
In the United States, hematopathology is a board-confirmed subspecialty by the American Board of Pathology. Board-qualified or board-guaranteed hematopathologists are typically pathology occupants (anatomic, clinical, or consolidated) who have finished hematopathology partnership preparing after their pathology residency. The hematopathology association endures it is possible that a couple of years. A doctor who practices hematopathology is known as a hematopathologist.
Sub tracks:
• Normal and reactive conditions of hematopoietic tissue • Normal bone marrow • Reactive lymphadenopathies • Normal lymphoid organs and tissues • Lymphoid neoplasms • Mature B cell neoplasms • Hairy cell leukemia • Mantle cell lymphoma • Myeloid neoplasms • Myelodysplastic syndromes • Acute myeloid leukemia
Tags
Histology Conferences
Molecular Pathology Conferences
Telepathology Conferences
Etiology Conferences
Pathology Conferences 2020 Middle East
Minimally-Invasive Procedures Conferences
Histopathology Conferences
Precision medicine Conferences
Medicine Conferences
Pathology Conferences 2020
Pathophysiology Conferences
Hemodynamics Conferences
Surgical Pathology Conferences 2020
Hematopathology Conferences
Pathology Meetings

Sub-atomic characteristics are an examination of heredity and assortment at the sub-nuclear level, particularly the segments of intrinsic transmission, and the assortment of gained properties among similar or related living things. It's focused on the stream and heading of inherited information between DNA, RNA, and proteins. It contains sub-fields generally genomics and proteomics. This amazing zone of bio science contributes on a very basic level to expanding our cognizance of science and empowers us to make bespoke discovering, treatment and sickness shirking for each patient subject to their own genetic make-up.
Sub tracks:
• Genetic transfer in prokaryotes • Isolation of plasmid DNA • Mutagenesis • Gene cloning • Gene expression
Tags
Ischemia Conferences
Cancer Pathology Conferences
Pathology Conferences 2020 USA
Oncology Conferences
General Medical Pathology Conferences
Molecular Pathology Conferences
Inflammation Conferences
Pathology Conferences 2020 Europe
Spectroscopy Conferences
Pulmonary Pathology Conferences
Diagnostic Immunology Conferences
Microscopy Conferences
Oral Pathology Conferences
Wound Healing Conferences
Medical Jurisprudence Conferences

Pediatric careful pathology is a part of pediatrics which manages all the careful activities of people beneath the age of 18. Pediatric medical procedure is principally isolated into these following classes, for example, cardiothoracic medical procedure, nephrological medical procedure, pediatric neurosurgery, pediatric urological medical procedure, nephrological medical procedure, hepatological medical procedure, orthopedic medical procedure, plastic medical procedure and oncological medical procedure. It might likewise include assessment of the atomic properties of tissue by immunohistochemistry.
Sub tracks:
• Radiation Pathology • Surgical and Autopsy Pathology • Biopsy and Transplantation Pathology • Advances in Surgical Pathology • Immunohistochemistry
Tags
Pulmonary Pathology Conferences
Speech-language Pathology Conferences
Pathology Conferences 2020 Asia
Oral and Maxillofacial Pathology Conferences
Hematology Conferences
Forensic Pathology Conferences
Ischemia Conferences
Clinical Chemistry Conferences
Pathology Conferences 2020
Diagnostic Immunology Conferences
Epidemiology Conferences
Anatomical Pathology Conferences
Histopathology Conferences
General Medical Pathology Conferences
Oncology Conferences

Head and Neck Pathology is that the space of surgical pathology that deals with disorders and conditions of the ear, nose and throat region and connected areas of the top and neck. the top and Neck Pathology additionally deals with membrane and Mesenchymal lesions of the higher aero digestive tube and lesions of the thyroid, endocrine, eye and orbit.Head and neck pathology helps within the differentiation of cancerous lesions from noncancerous lesions, and in correct designation of assorted infections, inflammations and different pathological conditions moving the top and neck region.
Sub tracks:
• Surgical Approaches for Larynx in Adults and Pediatrics • Rhinitis and Rhino sinusitis - Types and Treatment • Adenomatous v/s adenoma
Tags
Precision medicine Conferences
General Medical Pathology Conferences
Medical Microbiology Conferences
Medical Jurisprudence Conferences
Pathology Conferences 2020 Asia
Hematology Conferences
Pathogen Conferences
Spectroscopy Conferences
Inflammation Conferences
Cytopathology Conferences
Immunology Conferences
Speech-language Pathology Conferences
Hemodynamics Conferences
Oral Pathology Conferences
Clinical Chemistry Conferences
MARKET ANALYSIS
The worldwide computerized pathology market size was esteemed at USD 689.2 million out of 2018 and is relied upon to observe a CAGR of 11.7% during the conjecture time frame. Expanded spotlight on improving work process productivity and interest for quicker indicative instruments for ceaseless ailments, for example, malignancy, have been key variables driving the market. Rising commonness of constant conditions is foreseen to flood clinical earnestness to embrace advanced pathology to improve existing poor patient indicative imaging measures and to diminish significant expense related with regular diagnostics.
MARKET ANALYSIS IN USA:
This resuit considers the Pathology feature status and angle of Global and noteworthy regions, from edges of players, countries, thing types and end adventures; this report separates the top players in overall market, and parts the Pathology promote by thing type and applications/end organizations.
The overall Pathology market is regarded at xx million USD in 2017 and is depended upon to land at xx million USD before the completion of 2023, creating at a CAGR of xx% some place in the scope of 2017 and 2023. The mechanized pathology market spoke to $512 million of each 2018, and is depended upon to reach $1,390 million by 2026, enlisting a CAGR of 13.3% from 2019 to 2026. Propelled pathology is as an image based information setting by PC development that allows the administrators of information made through an automated slide. Digitalization of pathology has incited the computerization of tests during infection assurance among various applications.
MARKET ANALYSIS IN EUROPE:
The Europe Digital Pathology Market is expected to worth USD 49.9 million in 2018 and foreseen to reach USD 80.64 million by 2021, growing at a CAGR of 10%. The growing need for quality and patient safety has increased the demand for digital pathology around the world. which deals with the microscopic analysis of biological tissues to detect the presence of diseased cells/tissues. It involves the study of infinitesimal changes/aberrations in tissues that are caused due to some diseases. Histopathology tests are conducted in histopathology laboratories, wherein a pathologist studies changes or abnormalities in tissues caused by a disease.
MARKET ANALYSIS IN ASIA:
The worldwide anatomic pathology market is anticipated to achieve a size of $24.3 billion by 2024, advancing at a 5.8% CAGR during the gauge time frame.
The expanding pervasiveness of ceaseless illnesses, advancements in innovation, and flooding geriatric populace are a portion of the significant purposes for the development of the market. Based on application, the market is ordered into medication revelation, illness conclusion, and others. Out of these, the sickness analysis classification is relied upon to hold the biggest portion of over 65.0% in the market by 2024.
The worldwide anatomic pathology market is anticipated to accomplish a size of $24.3 billion by 2024, advancing at a 5.8% CAGR during the conjecture time frame. As per the report, worldwide advanced pathology market was esteemed at roughly USD 430 million out of 2017 and is required to produce income of around USD 980 million by end of 2024, developing at a CAGR of around 12% somewhere in the range of 2018 and 2024.
MARKET ANALYSIS IN MIDDLE EAST:
The worldwide advanced pathology market is anticipated to be esteemed at $383.9 Million of every 2016 and is relied upon to develop at a CAGR of 12.3% from 2017 to reach to $756.1 Million by 2022. Development in the general computerized pathology market is for the most part determined by components, for example, the developing utilizations of advanced pathology in medication improvement and friend diagnostics, simplicity of conference, expanding reception of computerized pathology to upgrade lab effectiveness, rising pervasiveness of malignant growth, and expanding activities by governments and industry players. Base year considered for the report is 2016 and the estimate time frame is 2017–2022.
Target Audience:
Pathologist | Research Practicing pathologist | Directors | Deans| Research Professionals| Laboratory heads| Lab managers| Lab technicians| Laboratory Professionals| Medical/ Biomedical scientists| Professors| Associate Professors | Assistant Professors| | Research Fellows| Medical students| Nurses| Residents.
List of Societies:
USA:
ASCP - American Society for Clinical Pathology | Association for Molecular Pathology | American Association for Physician Leadership | Association of American Physicians and Surgeons | Association of Internes and Medical Students | Association of Medical Illustrators | Association of Physicians of Pakistani Descent of North America | Association of LGBTQ Psychiatrists | Association of Academic Physiatrists | Association for the Treatment of Sexual Abusers | American Society for Gastrointestinal Endoscopy | American Society for Virology | American Society of Hematology | American Society of Cytopathology | American Society of Consultant Pharmacists | American Society of Clinical Oncology | Association of Pathology Chairs (APC) | Association of Clinical Pathologists (ACP) | Banff Foundation of Allograft Pathology (BFAP) | Canadian Hematology Society (CHS) | Canadian Association of Neuropathologists (CANP) | Canadian Association of Pathologists (CAP-ACP) | Canadian Society of Cytopathology (CSC) | Chilean Society of Anatomical Pathology (SCHAP) | Colombian Association of Pathology (ASOCOLPAT)
Europe:
European Medical Associations | Plant Pathology Associations | European Society of Pathology –ES P | Finland |European Helicobacter Study Group –EHSG | European Society for Agronomy | European Congress of Toxicologic Pathology | European Foundation for Plant Pathology | Austrian society of pathology | European Association for Potato Research Pathology Section | European Helicobacter Study Group | European Society for Agronomy | Association for European Cardiovascular Pathology (AECVP) | European Association of Haematopathology (EAHP) | European Federation of Cytology Societies (EFCS) | European Hematology Association (EHA) | European Network of Gastrointestinal Pathology (ENGIP) | European Association for Cancer Research (EACR) | European Society of Toxicologic Pathology (ESTP) | French Society of Pathology (SFP) | French Society of Senology and Mammary Pathology (SFSPM) | French Society of Toxicologic Pathology (SFTP) | German Professional Organization of Pathologists (BDP) | German Society of Cervical Pathology and Colposcopy (AG CPC) | German Society of Neuropathology and Neuroanatomy (DGNN) | Haematology Association of Ireland | World Immunopathology Organization (WIPO) | World Health Organization (WHO) | World Association of Societies of Pathology & Lab Medicine (WASPALM) | World Academy of Science, Engineering and Technology (WASET) | Vincent Academy of Pathology | Uruguay Society of Clinical Pathology (SUPAC) | University of Utah School of Medicine Department of Pathology (UOUDP) | United States & Canadian Academy of Pathology (USCAP) | UK Endocrine Pathology Society (UKEPS) | Turkish Society of Pathology (TPD) | Turkish Society of Hematology (THD) | Turkish Society of Blood Centers and Transfusion (TSBCT) | Turkish Society for Colposcopy and cervical Pathology (TRSCCP) | Tropical Pathology and Infectious Disease AssociationTM, Inc. |TPIDA) | Thrombosis and Hemostasis Societies of North America (THSNA) | Thrombosis & aemostasis Society of Australia & New Zealand (THANZ) | The Transplantation Society (TTS) | The Society for Colposcopy and Cervical Pathology of Singapore (SCCPS) | The Royal College of pathologists of Australasia (RCPA) | The Royal College of Pathologists (RCP) | The Joint Pathology Center (JPC) | The International Society of Dermatopathology (ISDP) | The International Association of Chinese Pathologists (IACP) | | The International Academy of Cytology (IAC) | The Dark Report (TDR) | The Cytometry Society, India (TCS) | Thai Society of cytology (TSC) | Taiwan Society of Pathology (TSP) | Taiwan Society of Clinical Pathology and Laboratory Medicine (TSCPLM) | Syrian Clinical Laboratory Association (SCLA) | Swiss Society of Toxicology (SST) | Swiss Society of Pathology (SSP) | Swiss Society of Neuropathology (SSN) | Swiss Society of Molecular Pathology (SSMP) | Swiss Society of Cytology (SGZ) | Swiss Society of clinical Chemistry (SSCC) | Swedish Society of Toxicology (SSoT) | Swedish Society of Pathology (SSP) | Swedish Society for Clinical Cytology (SSCC) | Swedish Association of Clinical Chemistry (SFKK) | Spanish Society of Thrombosis and Hemostasis (SETH) | Spanish Society of Senology | Breast Pathology (SESPM) | Spanish Society of Forensic Pathology (SEPAF) | Spanish Society of Digestive Pathology (SEPD) | Spanish Society of Cytology (SEC) | Spanish Society of Anatomical Pathology and Spanish Division of the IAP (SEAP) | Spanish Society for Clinical Biochemistry and molecular Pathology (SEQC) | Spanish Association of the Study of the Liver (AEEH) | Spanish association of Paleopathology (AEP) | Spanish Association of Medical Biopathology (AEBM) | Spanish Association of Cervical Pathology and Colposcopy (AEPCC) | Southern African Transplantation Society (SATS) | South African Society of Clinical Cytology (SASCC) | South African Association for Clinical Biochemistry (SAACB) | Society of Toxicology (SOT) | Society of Toxicologic Pathology (STP) | Society of Thrombosis and Haemostasis Research (GTH) | Society of Forensic Toxicologists (SOFT) | Society of Electron Microscope Technology (SEMT) | Society of Cytopathology (Turkey) (SPD) | Society for Ultrastructural Pathology (SUP) | Society for toxicologic Pathology in India (STPI) | Society for Pediatric Pathology (SPP) | Society for Histochemistry (SFH) | Society for Hematopathology (SH) | Society for General Microbiology (SGM) | Society for Cardiovascular Pathology (SCVP) | Societa Italiana & Patelogia Clinica e Medicina di Laboratorio (SIPMeL) | Sociedad Española de Senología y Patología Mamaría (SPSPM) | Slovenian Society of Pathology and Forensic Medicine (SSPFM) | Slovenian ssociation for Clinical Chemistry (SACC/SZKK) | Slovak Society of Pathologists (SSP) | Singapore Society of Pathology (SSP) | Singapore Association for Medical Laboratory Sciences (SAMLS) | Serbian Society of Toxicology (SETOX) | Scottish Pathology Network (SPAN) | Scottish Haematology Society (SHS) | Scientific Federation | Scandinavian Neuropathological Society (SNS) | Scandinavian Fellowship for Oral Pathology and Oral Medicine (SFOPOM) | Saudi Society of Nephrology and Transplantation (SSNT) | Saudi Scientific Hematology Society (SSHS) | Royal College of Pathologists of Thailand (RCPT) | Romanian Society of Laboratory Medicine (SRML) | Rodger C. Haggitt Gastrointestinal Pathology Society (GIPS) | Copenhagen University Hospital (RH) | Research Institute of Molecular Pathology (IMP) | Renal Pathology Society (RPS) | Pulmonary Pathology Society (PPS) | Portuguese Society of Spinal Pathology (SPPCV) | Portuguese Society of Hematology (SPH) | Portuguese Society of Cytology (SPC) | Portuguese Society of Clinical Pathology (SPPC) | Portuguese Society of Anatomical Pathology (SPAP) | Portuguese Association of Technicians of Anatomical Pathology (APTAP) | Portuguese Association of Medical Pathologists (APOMEPA) | Portuguese Association of Experimental Pathology (PATOLEX) | Philippine Society of Pathologists (PSP) | Pezcoller Foundation (PF) | Peruvian Medical Association of Clinical Pathology (PMACP) | Pathology Society of Emirates Medical Association (PSEMA) | Pathology Education Partners (PEP) | Pathological Society of Great Britain & Ireland (PathSoc) | PathoIndiaPapanicolaou Society of Cytopathology (PSC) | Pan Arab Hematology Association (PAHA) | Pan American Society for Clinical Virology (PASCV) | Paleopathology Association (PPA) | Pakistan Society of Hematology (PSH) | Pakistan Association of Pathologists (PAP) | Paediatric Pathology Society (PPS) | Oman Society of Pathology (OSP) | Norwegian Society of Clinical Cytology (NFKC) | Norwegian Pathologist Association (DNP) | North American Specialized Coagulation Laboratory Association (NASCOLA) | North American Society for Head & Neck Pathology (NASHNP) | North American Chinese Clinical Chemists Association (NACCCA) | Nordic Society of Clinical Microbiology and Infectious Diseases (NSCMID) | Nordic Society for Clinical Chemistry (NFKK) | Nordic mmunohistochemical Quality Control (NordiQC) | Nigeria Society of Haematology & Blood Transfusion (NSHBT) | New Zealand Institute of Medical Laboratory Science (NZIMLS) | New Zealand Committee of Pathologists (NZCP) | Neuropathology Society of India (NPSI) | Netherlands Society of oxicology (NVT) | Netherlands Society for Thrombosis and Haemostasis (NVTH) | Netherlands Society for Clinical Chemistry and Laboratory Medicine (NVKC) | National Society for Histotechnology (NSH) | National Pathology Group of South Africa (NPG-SA) | National Association of athologists in Guatemala (ANP-G) | National Association of Medical Examiners (NAME) | National Association of Clinical Laboratories (NACL) | National Accrediting Agency for Clinical Laboratory Sciences (NAACLS) | Moroccan Society of Clinical Chemistry (SMCC) | Molecular Pathology Association of India (MPAI) | Molecular & Experimental Pathology Society of Australasia (MEPSA) | Microscopy Society of Southern Africa (MSSA) | Microscopy Society of America (MSA) | Microscopy New Zealand (MNZ) | Mexican Federation of Clinical Pathology (FEMPAC) | Mexican Council of Clinical Pathology AC (COMPAC) | Mexican College of Gynecologists Dedicated to Colposcopy (COMEGIC) (formerly AMCPC) | Mexican Association of Technicians in Pathobiology,(AMETEP) | Mexican Association of Pathologists, (MAP AC) | Mexican Association of Oral Pathology and Medicine (AMPMB) | emorial Sloan Kettering Cancer Center (MSKCC) | Mediterranean League Against Thromboembolic Diseases (MLTD) | Mayo Foundation for Medical Education and Research (MFMER) | Macedonian Association of Pathology | Lithuanian National Centre of Pathology (NCP) | Lebanese Society of Pathology (LSP) | Le Collège Français de Pathologie Vasculaire (CFPV) | Latin American Society of Vulvovaginal Pathology (SOLAPAV) | Latin American Society of Pathology (SLAP) | Latin American Society of Cytopathology (SLAC) | Latin American Society for Pediatric Pathology (SLAPPE) | Latin American Federation for the Pathology of the Lower Genital Tract and Colposcopy (FLPTGIC) | Latin American Association for Clinical Pathology and Laboratory Medicine (ALAPC) | Laennec Liver Pathology Society (LLPS) | Korean Society on Thrombosis and Hemostasis (KSTH) | Korean Society of Toxicology (KSOT) | Korean Society of Pathologists (KSP) | Korean Society of Clinical Microbiology (KSCM) | Korean Society of Clinical Chemistry (KSCC) | Korean Society of Blood Transfusion (KSBT) | Korean Society for Laboratory Medicine (KSLM) | Korean Society for Cytopathology (KSC) | Jornada de Patología OncológicaJapanese Society on Thrombosis and Hemostasis (JSTH) | Japanese Society of Toxicologic Pathology (JSTP) | Japanese Society of Pathology (JSP) | Japanese Society of Oral Pathology (JSOP) | Japanese Society of Neuropathology (JSNP) | Japanese Society of Laboratory Medicine (JSLM) | Japanese Society of Histochemistry and Cytochemistry (JSHC) | Japanese Society of Hematology (JSH) | Japanese Society of Digital Pathology (JSDP) | Japanese Society of Clinical Cytology (JSCC) | Japanese Association of Clinical Laboratory Physicians (JACLAP) | Japan Society of Brain Tumor Pathology (JSBTP) | Italian Society of Transfusion Medicine and Immunohematology (SIMTI) | Italian Society of Toxicology (SITOX) | Italian Society of Oral Pathology and Medicine (SIPMO) | Italian Society of Coloscopy and Cervical Pathology (SICPVC) | Italian Society of Clinical Biochemistry and Clinical Molecular Biology (SIBioC) | Italian Society of Anatomic Pathology and Diagnostic Cytopathology (SIAPEC-IAP) | Italian Society for the Study of Haemostasis and Thrombosis (SISET) | Italian Pathology and Translational Medicine Society (SIPMET) | Italian Association of Neuropathology and Clinical Neurobiology | Italian Association of Clinical Pathology and Molecular Medicine (AIPACMEM) | Israel Society of Hematology and Blood Transfusion (ISHBT) | Irish Society of Surgical Pathology (ISSP) | Iranian Society of Toxicology (IST) | Iranian Society of Pathology (ISP) | Iranian Society of Colposcopy and Cervical Pathology (ISCCP) | Iranian Society of Clinical Cytology (ISCC) | Iranian Society of Blood Transfusion (ISBT) | Iranian Blood Transfusion Organization (IBTO) | Iranian Association of Oral and Maxillofacial Pathology (IAAOMP) | Intersociety Council for Pathology Information (ICPI) | International Union of Toxicology (IUTOX) | International Society on Thrombosis & Haemostasis (ISTH) | International Society of Urological Pathology (ISUP) | International Society of Neuropathology (ISN) | International Society of Laboratory Hematology (ISLH) | International Society of Hematology (ISH) | International Society of Heart and Lung Transplantation (ISHLT) | International Society of Breast Pathology (ISBP) | International Society of Bone & Soft Tissue Pathology (ISBSTP) | International Society of Blood Transfusion (ISBT) | International Society for Pathophysiology (ISP) | International Society for Gynecological Pathologists (ISGP) | International Society for Experimental Hematology (ISEH) | International Society for Biological and Environmental Repositories (ISBER) | International Society for Apheresis (ISFA) | International Society for Advancement of Cytometry (ISAC) | International Plasma Fractionation Association (IPFA) | International Pediatric Nephrology Association (IPNA) | International Paediatric Pathology Association (IPPA) | International Medical Informatics Association (IMIA) | International Federation of Societies of Toxicologic Pathologists (IFSTP) | International Federation of Human Genetics Societies (IFHGS) | International Federation of Clinical Chemistry and Laboratory Medicine (IFCC) | International Federation of Cervical Pathology and Colposcopy (IFCPC) | International Federation of Biomedical Laboratory Science (IFBLS) | International Extranodal Lymphoma Study Group (IELSG) | International Clinical Cytometry Society (ICCS) | International Association of Oral Pathologists (IAOP) | International Academy of Toxicologic Pathology (IATP) | International Academy of Pathology (IAP) | International Academy of Pathology (IAP-TD) | International Academy of Pathology (IAP-SAD) | International Academy of Pathology - Romanian Division (IAP-RD) | International Academy of Pathology - Malaysian Division IAP(IAPMD) | Indonesian Association of Clinical Pathologists (IACP) | Indian Society of Renal and Transplantation Pathology (ISRTP) | Indian Society of Colposcopy and Cervical Pathology (ISCCP) | Indian Association of Pathologists and Microbiologists (IAPM) | Indian Association of Oral & Maxillofacial Pathologists (IAOMP) | Indian Association of Forensic Medicine (IAFM) | Indian Academy of Cytologists (IAC) | Ibero-Latin American Dermatopathology Society (SILADEPA) | Hungarian Society of Pathology (HSP) | Human Genetics Society of Australasia (HGSA) | Hong Kong Society of Histocompatibilty and Immunogenetics (HKSHI) | Histopathology & Cytology Society of Pakistan (HCSP | Histochemical Society (HCS) | Histiocyte Society (HS) | Hemostasis Thrombosis Research Society (HTRS) | Hellenic Society of Oral Medicine and Pathology (EEPS-HSOMP) | Hellenic Society of Hematology (EAE) | Hellenic Society for Colposcopy and Cervical Pathology (HSCCP) | Healthcare Information and Management Systems Society (HIMSS) | Health Informatics Society of Sri Lanka (HISSL) | Health Informatics Society of Australia (HISA) | Hans Popper Hepatopathology Society (HPHS) | Haematology Society of Australia & New Zealand (HSANZ) | Haematology Association of Ireland (HAI) | Group for Research In Pathology Education (GRIPE) | Greek Society of Pathology (EEPA) | Greek Society for Clinical Chemistry and Clinical Biochemistry (EEKCH-CG) | Great Lakes International Imaging and Flow Cytometry Association (GLIIFCA) | Global Engage Ltd | German Society of Pathology (DGP) | German Society of Neuropathology and Neuroanatomy (DGNN) | German Society of Cytology (GSC) | German Society of Cervical Pathology and Colposcopy (AG CPC) | German Society for Transfusion Medicine and Immunohematology (DGTI) | German Society for Thrombosis and Haemostasis (GTH) | German Society for Electron Microscopy (DGE) | German Society for Cytometry (DGfZ) | German Society for Clinical Chemistry and Laboratory Medicine (DGKL) | German Professional Organization of Pathologists (BDP) | French Society of Toxicologic Pathology (SFTP) | French Society of Senology and Mammary Pathology (SFSPM) | French Society of Pathology (SFP) | French Society of Colposcopy and Cervico-Vaginal Pathology (SFCPCV) | French Society of Clinical Cytology (SFCC) | French College of Vascular Pathology Flow Cytometry UK (FC) | Finnish Association of Clinical Chemistry (SKKY) | Federation of urkish Pathology Societies (FTPS) | Federation of South African Societies of Pathology (FSASP) | Federation of European Toxicologists & European Societies of Toxicology (EuroTox) | Federation of Anatomical Pathology of the Republic of Mexico AC (FEDPATMEX) | European, Middle-Eastern and African Society for Biopreservation and Biobanking (ESBB) | European Society of Toxicologic Pathology (ESTP) | European Society of Pathology (ESP) | European Society of Human Genetics (ESHG) | European Society of Dermatopathology (ESDP) | European Society for Clinical Cell Analysis (ESCCA) | European Renal Association - European Dialysis and Transplant Association (ERA-EDTA) | European Network of Gastrointestinal Pathology (ENGIP) | European Microscopy Society (EMS) | European Hematology Association (EHA) | European Group for Blood and Marrow Transplantation (EBMT) | European Federation of Neurological Societies (EFNS) | European Federation of Cytology Societies (EFCS) | European Federation of Clinical Chemistry and Laboratory Medicine (EFLM) | European Federation for Medical Informatics (EFMI) | European Federation for Immunogenetics (EFI) | European Federation for Colposcopy and Pathology of the Lower Genital Tract (EFC) | European Confederation of Neuropathological Societies (ECNS) | European Association of Haematopathology (EAHP) | European Association for the Study of the Liver (EASL) | European Association for Cancer Research (EACR) | Endocrine Pathology Society (EPS) | Emirates Society of Haematology (ESH) | Ecuadorian Society of Pathology of the Lower | Ecuadorian Society of Pathology (SEP) | Ecuadorian Society of Clinical Pathology and Laboratory Medicine (SEPCLM) | Dutch Society for Cytometry (NVC) | Digital Pathology Association (DPA) | Dermatopathology Society of India (DSI) | Danish Society of Hematology (DSH) | Danish Society for Thrombosis and Haemostasis (DSTH) | Danish Society for Flow Cytometry (DSFCM) | Danish Society for Clinical Biochemistry (DSKB) | Danish Pathology Society (DPAS) | Czecho-Slovak Society of Pathology (CSSP) | Czech Society of Clinical Biochemistry (CSCB) | Czech Society for Cervical Pathology and Colposcopy (CSCPC) | Czech Pathologists JEP (CPJEP) | Cuban Society of Hematology (CSH) | Cuban Society of Clinical Pathology (SCPC) | Cuban Society of Anatomical Pathology (SCAP) | Croatian Society of Pathology (HDPSM) | Colombian Association of Pathology (ASOCOLPAT) | Academy of Medicine of Malaysia (AMM) | College of American Pathologists (CAP) | Clinical Laboratory Management Association (CLMA) | Clinical and Laboratory Standards Institute (CLSI) | Chinese Society Of Toxicology (CST) | Chinese Pathology Association (CPA) | Chinese American Pathologists Association (CAPA) | Chilean Society of Anatomical Pathology (SCHAP) | Canadian Society of Nephrology | Canadian Society of Cytopathology (CSC) | Canadian Society of Clinical Chemists (CSCC) | Canadian Society for Transfusion Medicine (CSTM) | Canadian Society for Medical Laboratory Science (CSLMS | Canadian Hematology Society (CHS) | Canadian Association of Pathologists (CAP-ACP) | Canadian Association of Neuropathologists (CANP) | Canadian Association for the Study of the Liver (CASL) | Canadian Association For Clinical Microbiology and Infectious Diseases (CAMCID) | Canada's Health Informatics Association (COACH) | Bulgarian Society of Clinical Laboratory (BSCL) | Bulgarian Pathology Association (BPA) | British Toxicology Society (BTS) | British Society of Toxicologic Pathology (BSTP) | British Society of Oral & Maxillo-facial Pathologists (BSOMP) | British Society of Haemostasis & Thrombosis (BSHT) | British Society of Gastroenterology (BSG) | British Society for Histocompatibility & Immunogenetics (BSHI) | British Society for Haematology (BSH) | British Society for Dermatopathology (BSD) | British Society for Colposcopy and Cervical Pathology (BSCCP) | British Neuropathological Society (BNS) | British Lymphoma Pathology Group (BLPG) British Blood Transfusion Society (BBTS) | British Association of Urological Pathologists (BAUP) | British Association of Gynaecological Pathologists (BAGP) | British Association of Dermatologists | British Association for Study of the Liver (BASL) | British Association for Ophthalmic Pathology (BAOP) | British Association for Cytopathology (BAC) | Brazilian Society of Stomatology and Oral Pathology (SOBEP) | Brazilian Society of Pathology (SBP) | Brazilian Society of Cytopathology (SBC) | Brazilian Society of Clinical Pathology and Laboratory Medicine (SBPC/ML) | Brazilian Association of Colposcopy and PTGI (ABPTGIC) | Brazilian Association of Anatomical Pathology and Cytopathology Laboratories (ABRALAPAC) | Binford-Dammin Society of Infectious Disease Pathologists (BDSIDP) | Belgian Society of Pathology (BSP) | Belgian Hematological Society (BHS) | Banff Foundation of Allograft Pathology (BFAP) | Balkan Clinical Laboratory Federation (BCLF) | Austrian Society of Pathology (OGP) | Austrian Society of Neuropathology (OEGNP) | Austrian Society of Gastroenterology and Hepatology | Austrian Society of Cytology (Österreichische Gesellschaft für Zytologie) (OGZ) | Austrian Association for Laboratory Medicine and Clinical Chemistry (ÖGLMKC) | Australian Society of Cytology Inc (ASC) | Australian Society for Microbiology (ASM) | Australian Society for Colposcopy and Cervical Pathology (ASCCP) | Australian Society for Breast Disease (ASBD) | Australian & New Zealand Society of Cardiac & Thoracic Surgeons (ANZSCTS) | Australian & New Zealand Society of Blood Transfusion (ANZSBT) | Australia and New Zealand Forensic Science Society (ANZFSS) | Australasian Society of Thrombosis and Haemostasis (ASTH) | Australasian Society for Breast Disease (ASBD) | Australasian Immunohistochemistry Society (AIS) | Australasian Gastrointestinal Pathology Society (AGPS) | Australasian Dermatopathology Society (ADS) | Australasian Cytometry Society (ACS) | Australasian Association of Clinical Biochemists (AACB) | Associazione Italiana de Neuropatologia (AINP) | Association of Public Health Laboratories (APHL) | Association of Pathology Chairs (APC) | Association of Medical Microbiology and Infectious Disease Canada (AMMI) | Association of Medical Laboratory Immunologists (AMLI) | Association of Indian Pathologists in North America (AIPNA) | Association of German Pathologists eV (BDP eV) | Association of Directors of Anatomic and Surgical Pathology (ADASP) | Association of Clinical Scientists (ACS) | Association of Clinical Pathologists (ACP) | Association of Clinical Chemistry and Laboratory Medicine of Ukraine (ACCLMU) | Association of Clinical Biochemists of India (ACBI) | Association of Clinical Biochemists in Ireland (ACBI) | Association of Anatomical Pathology Technology (AAPT) | Association for Pathology Informatics (API) | Association for Molecular Pathology (AMP) | Association for European Cardiovascular Pathology (AECVP) | Association for Clinical Cytogenetics (ACC) | Association for Clinical Biochemistry and aboratory Medicine (ACB) | Association Bulgarian Clinical Toxicology (ABgCT) | Asia-Pacific Histocompatibility and Immunogenetics Association (APHIA) | Asia-Pacific Association of Medical Informatics (APAMI) | Asian-Pacific Society of Thrombosis and Hemostasis (ASPTH) | Asian-Pacific Federation for Clinical Biochemistry and Laboratory Medicine (APFCB) | Asian Society of Toxicology (AsiaTOX) | Asian Pacific Society of Cardiology | Asia Pacific Coroners' Society (APCS) | Asia Pacific Association of Medical Toxicology (APAMT) | Asia Pacific Association for the Study of the Liver (APASL) | Arthur Purdy Stout Society of Surgical Pathologists (APSSSP) | Argentinean Society of Pathology of the Inferior Genital Tract and Colposcopy (ASPIGTC) | Argentinean Society of Cytology (SAC) | Argentina Society of Pathology | American Society of Human Genetics (ASHG) | American Society of Hematology (ASH) | American Society of Dermatopathology (ASDP) | American Society of Cytopathology (ASC) | American Society of Colposcopy & Cervical Pathology (ASCCP) | American Society for Virology (ASV) | American Society for Microbiology (ASM) | American Society for Investigative Pathology (ASIP) | American Society for Histocompatibility and Immunogenetics (ASHI) | American Society or Cytotechnology (ASCT) | American Society for Clinical Pathology (ASCP) | American Society or Clinical Laboratory Science (ASCLS) | American Society for Apheresis (ASFA) | American Pathology Foundation (APF) | American Pancreatic Association (APA) | American Osteopathic College of Pathologists, Inc. (AOCP) | American Medical Informatics Association (AMIA) | American College of Toxicology (ACT) | American Clinical Laboratory Association (ACLA) | American Board of Pathology (ABP) | American Association of Pathologists' Assistants (AAPA) | American Association of Ophthalmic Oncologists and Pathologists (AAOOP) | American Association of Neuropathologists (AANP) | American Association of Immunologists, Inc. (AAI) | American Association of Blood Banks (AABB) | American Association of Bioanalysts (AAB) | American Association for the Study of Liver Diseases (AASLD) | American Association for Clinical Chemistry (AACC) | American Academy of Oral and Maxillofacial Pathology (AAOMP) | American Academy of Forensic Sciences (AAFS) | American Academy of Clinical Toxicology (AACT) | Allied Academies (A.A) | Albanian Society of Clinical Biochemistry and Laboratory Medicine (ASoLaM) | African Society for Laboratory Medicine (ASLM) | African Society for Blood Transfusion (AFSBT) | Academy of Clinical Laboratory Physicians & Scientists (ACLPS).
List of Universities:
USA:
Ohio state of university | Pennsylvania State University | Michigan State University | New York University | University of Wisconsin – Madison | University of Michigan - Ann Arbor | University of Washington | University of California | University of California | University of Southern California
Europe:
University of Aberdeen | Durham University | University of Edinburgh | University of Glasgow | Glyndwr University, Wrexham | Harper Adams University | Manchester Metropolitan University | Manchester Metropolitan University | Queen's University Belfast | Queen's University Belfast | Cardiff Metropolitan University | Imperial College London Medicine | King's College London, University of London | University of Leeds school of Medicine | University of Leicester Cancer Studies and Molecular Medicine | University of Manchester Faculty of Biology, Medicine and Health | University of Manchester school of Medical Sciences | Middlesex University Biomedical and Biological Sciences | University of Oxford Clinical Medicine | University of Oxford Pathology | Queen Mary University of London Barts Cancer Institute | Queen Mary University of London Blizard Institute | École Poly technique | Sorbonne University | Centrale Supélec | École Normale Supérieure de Lyon | Sciences Po Paris | Télé com Paris Tech | École des Ponts Paris Tech | University of Paris | Université Paris-Sud
Middle East:
Gulf medical universaity | The university of Jordan | lehman university | Rocky mountain university of health professions
List of Hospitals:
USA:
Jackson Memorial Hospital Pathology | Children's Hospital Philadelphia: Pathology | Carle Foundation Hospital Pathology | Aventura Hospital and Medical Center | Emory University Hospital | Children's Hospital Los Angeles | Howard University Hospital Pathology | Saint Josephs Hospital Pathology | West Virginia University Hospital Pathology | Rhode Island Hospital Pathology | Danbury Hospital-Pathology | Phelps Memorial Hospital Center Pathology | Brattleboro Memorial Hospital Pathology | Kings County Hospital: Pathology
Europe:
Clinical Centre of Serbia | Charite – Universitatsmedizin Berlin | Helsinki University Central Hospital | Motol University Hospital | Sahlgrenska University Hospital | Vienna General Hospital | Semmelweis University Hospital | University Hospitals of Geneva | University Hospital Pilsen | LKH Klagenfurt | University Medical Center Freiburg
Middle East:
NMC Specialty Hospital | NMC Royal Hospital | Al Zahra Hospital | NMC Royal Women's Hospital | Fakih IVF | Provita | NMC Specialty Hospital | NMC Royal Hospital | B. R. Medical Suites | Cooper Health Clinic | NMC Medical Centre, Deira | The American Surgecenter | NMC Specialty Hospital | Americare | Sheikh Khalifa General Hospital
List of Journals:
Journal of Clinical Pathology | The Journal of Pathology Indian Journal of Pathology & Microbiology | Indian Journal of Pathology & Microbiology | International Journal of Surgical Pathology | International Journal of Clinical and Experimental Pathology | The American Journal of Pathology | Archives of Pathology & Laboratory Medicine | Human Pathology | The American Journal of Surgical Pathology | American Journal of Clinical Pathology | Brain Pathology | Ultrastructural Pathology | Toxicologic Pathology | Histology & Histopathology | Neuropathology and Applied Neurobiology | The American Journal of Forensic Medicine and Pathology | Journal of Neuropathology & Experimental Neurology | Histopathology | Pediatric and Developmental Pathology | Acta Neuropathologica | Journal of Pathology Informatics | American Journal of Dermatopathology | Diagnostic pathology journal | Acta psychopathologica journal | cellular and molecular pathology journal | clinical pathology journal | Journal of Speech Pathology and Therapy | Journal of Cutaneous Pathology | Journal of Pathology Informatics | Journal of Cutaneous Pathology | Plant Pathology | Oral Surgery, Oral Medicine, Oral Pathology, and Oral Radiology | Molecular Plant Pathology | Australasian Plant Pathology | Cancer Cytopathology | Journal of Invertebrate Pathology | Forest Pathology | Journal of Clinical & Experimental Pathology | Journal of Clinical & Experimental Ophthalmology | International Journal of Ophthalmic Pathology | Journal of Plant Physiology & Pathology | Journal of Virology & Antiviral Research | Journal of Clinical & Experimental Oncology | Diagnostic Pathology | Immunochemistry and Immunopathology | Journal of Speech Pathology & Therapy | Acta Psychopathologica | Journal of MPE Molecular Pathological Epidemiology | Journal of Molecular Histology & Medical Physiology | Journal of Cellular & Molecular Pathology
List of companies:
USA:
Alere, Inc | Bio-Reference Laboratories | Smith & Nephew plc | DENTSPLY SIRONA Inc | Edwards Lifesciences Corp | Hologic Inc | Intuitive Surgical Inc | Danaher Corp | Hill-Rom Holdings Inc | Varian Medical Systems Inc | Steris PLC | The Cooper Companies Inc | ResMed Inc | Abbott Laboratories | Accriva Diagnostics Accubiotech Co, Ltd. | Acon Laboratories, Inc | Alere Inc | Arkray | Atlas Genetics Ltd. | Atlas Link Biotech Co., Ltd. | Beckman Coulter, Inc. | Bioptix, Inc | Biomeme, Inc | Biomerieux SA | Cepheid | Chembio Diagnostic Systems, Inc. | Church & Dwight Co. Inc | Danaher Corporation | Abbott Laboratories | Stryker Corp | Becton, Dickinson and Co | Baxter International Inc | Boston Scientific Corp | Zimmer Biomet Holdings Inc | 3M Co | Genomic Health, Inc | Laboratory Corporation of America | Myriad Genetics, Inc | NeoGenomics, Inc | Sonic Healthcare Limited | Medtronic plc | Johnson & Johnso Fresenius Medical Care AG & Co. KGAAn | General Electric Co | Cardinal Health Inc
Europe:
Teleflex Inc | Paul Hartmann AG | Coloplast A/S | bioMérieux S.A | Sonova Holding AG | Getinge AB | Novartis AG | Essilor International Société Anonyme | Siemens AG | Koninklijke Philips N.V | SYNLAB International GMBH | Siemens Healthineers
Asia:
Fujifilm Holdings | GE Healthcare | Siemens Healthcare | Philips Healthcare | Shimadzu Corporation | Toshiba Medical Systems Corporation | Carestream Health | Hitachi Medical Corporation | Hologic | Esaote | Dragerwerk AG & Co. KGaA | Sysmex Corp | Nipro Corp | HOYA Corp | Canon Inc | Terumo Corp | Olympus Corp
Contact us now and we will make your event unique & unforgettable
All numbers indicates percentage %
Europe
North America
Middle East
Asia Pacific
Africa
All numbers indicates percentage %
Pathologists
Medical Biomedical Scientists
Research Professionals
Microbiologists
Doctors
Nurses
Pharmacists
AssistantAssociate Professors


